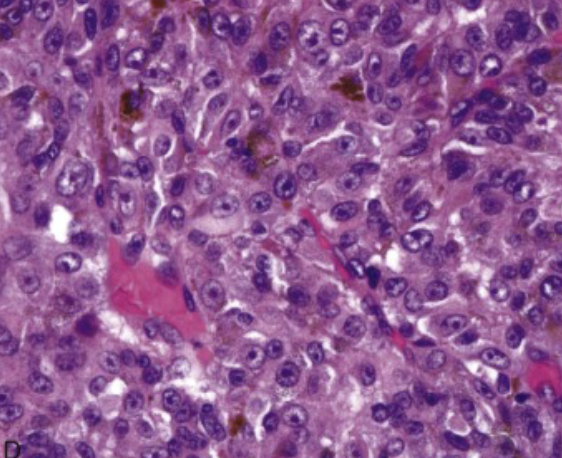

keratoconus
_______(2 diz) are the leading causes of corneal transplantation
- Fuchs dystrophy
- Pseudophakia bulbous keratopathy
(corneal edema → vision loss)
Mutations in the ______ gene lead to juvenile and adult primary open angle glaucoma.
myocilin (MYOC)
Weber syndrome (secondary open angle glaucoma)
increase in episcleral venous pressure (due to vascular malformations)
Panophthalmitis involves ______ (3 structures) and extends into the orbit.
- choroid
- scleris
- retina
________ mutation is common in juvenile glaucoma
OPTN

uveal melanoma

melanoma with ruptured Bruch’s membrane

ruptured Bruch’s membrane & retinal detachment
epithelioid melanoma cells (spherical)
Retinopathy of prematurity
full term babies that do not have vascularization of the temporal portion of the retina
(retinal tissue distal to this → ischemic)
Salmon patches, seafan, sunburst lesions and iridescent spots are indicative of ______.
sickle cell retinopathy


